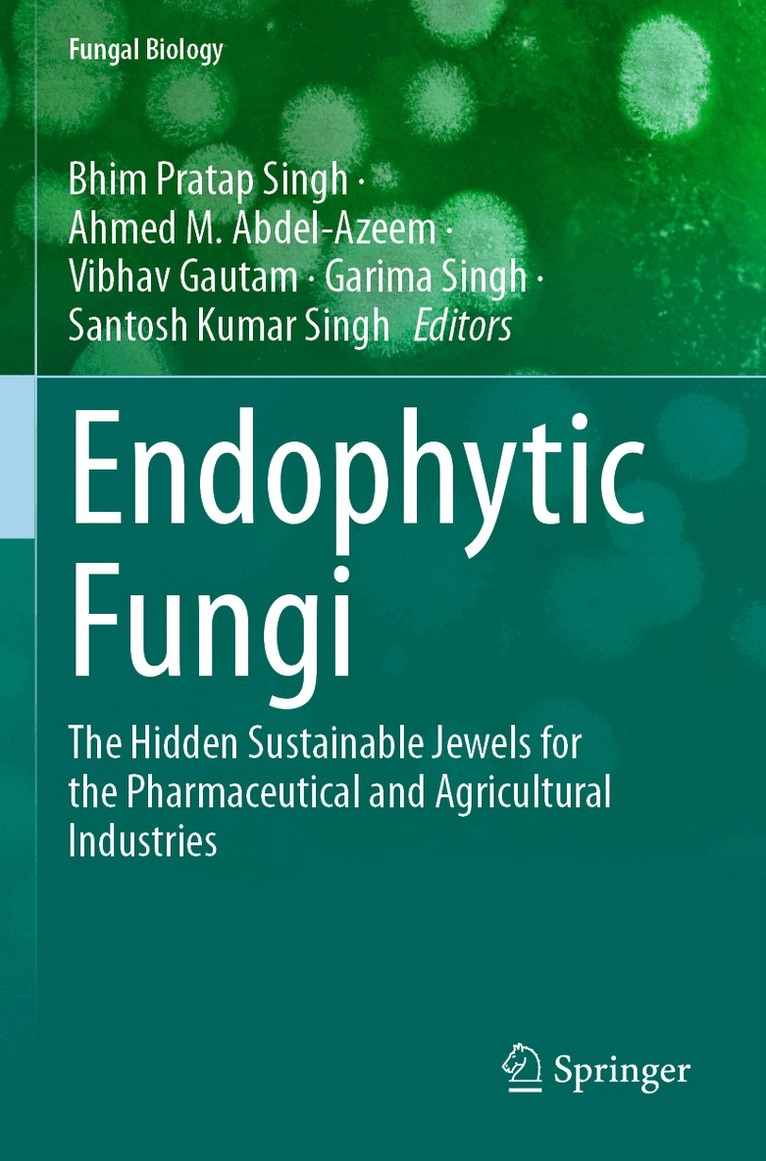
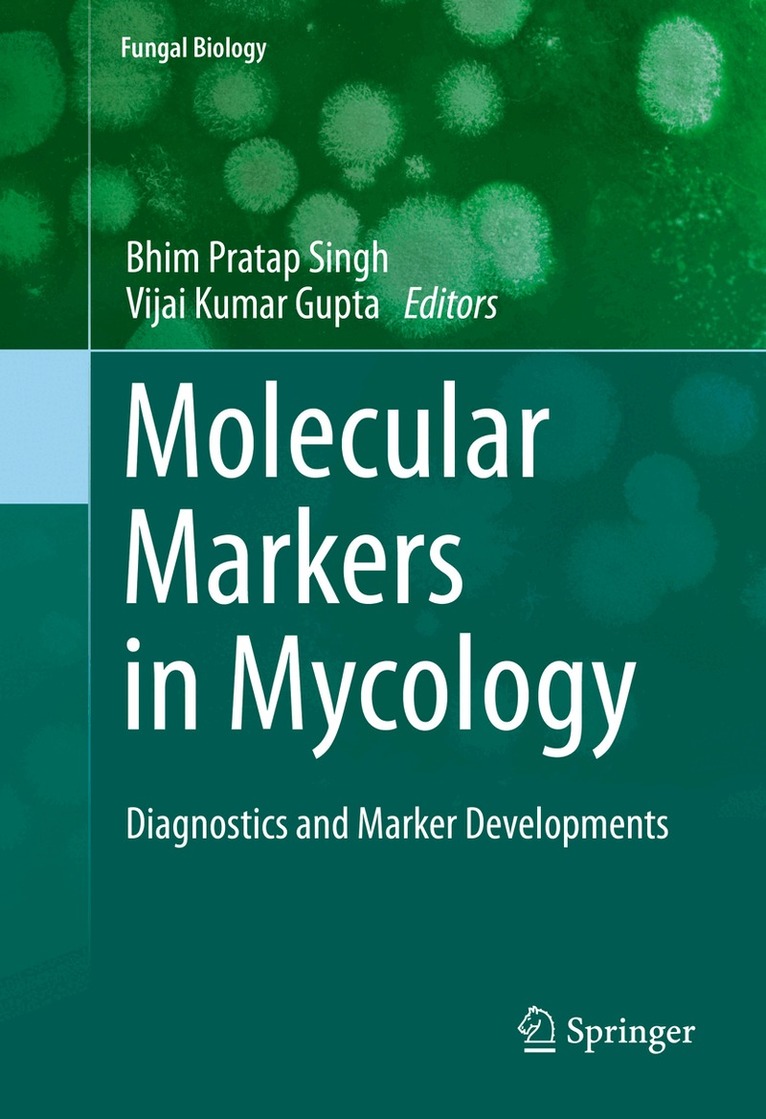

Bhim Pratap Singh – författare
1 630 kr
Skickas inom 10-15 vardagar
Microbial Endophytes and Plant Growth: Beneficial Interactions and Applications explains how modern molecular tools can unlock the plant's microbial network, building the bridge between plant and environment. Chapters describe the usefulness of the endophytic microbiome of different crops, including cereals, vegetables and horticulture, and delve into the latest research surrounding the applications of plant-microbe interactions in improving plant growth. Other topics discussed include root endophytes and their role in plant fitness, seed associated endophytes and their functions, and microbial endophytes and nanotechnology.
This is a one-stop resource for scientists wanting access to the latest research in plant microbiology. The book also provides advanced techniques for using multi-omics approaches to study plant-microbe interactions, providing readers with a practical approach.
Outlines multi-omics approaches to study plant endophytes interactions Describes the efficacy of endophytes to combat biotic and abiotic factors Defines the prominent role of endophytic microbes to improve plant growth1 390 kr
Skickas inom 10-15 vardagar
Postharvest Management of Fresh Produce: Recent Advances critically addresses the latest issues, challenges, and technological advancements in postharvest management of fresh commodities, especially fruits, nuts, and vegetables. The book covers the intriguing correlation of preharvest treatments, maturity indices and postharvest operations that significantly affect the postharvest quality of fresh produce. Further topics include packaging, logistics and storage technologies, the role of microbial communities, and 'omics' strategies in postharvest disease management. Special attention is given to the latest trends of nanotechnology, internet of things (IoTs), and blockchain technologies in food supply chain management of perishable products.
The book is a great resource for young and experienced professionals in academia, industry, and UG/PG students to explore a diversified range of topics in postharvest strategies relevant to food processing, food technologies, agro-processing and quality control.
Thoroughly explores major preharvest losses due to non-availabilities of the latest technologies Describes the latest trends in the supply chain to minimize preharvest losses Provides an overview on smart technologies such as nanotechnology, IoTs and blockchain technology2 403 kr
Läs direkt efter köp
1 975 kr
Läs direkt efter köp
2 171 kr
Skickas inom 10-15 vardagar
Actinobacteria: Diversity and Biotechnological Applications: New and Future Developments in Microbial Biotechnology and Bioengineering, a volume in the series New and Future Developments in Microbial Biotechnology and Bioengineering series, offers the latest on the biotechnology of Kingdom actinobacteria, covering unique niches like their endosphere, rhizospheric soil and contaminated sites, etc. The book also covers the bioactive secondary metabolites obtained from actinobacteria and describes the application of microorganism (Actinobacteria) in plant growth promotion and in environmental cleanup. Finally, the book describes the biocontrol aspects of actinobacteria and how they can control fungal phytopathogens and the production of secondary metabolites.
Includes an overview of all types of actinobacteria, source and enzymatic activity Lists various bioengineering methods for the production of these enzymes Reviews numerous industrial applications of actinobacteria, i.e., crop improvement, removal of heavy metals, etc. Offers unique coverage of the application of actinobacteria in bioremediation processes Explores the plant growth promoting potential of endophytic actinobacteria Describes biosynthetic potential genes associated with actinobacterial genome3 092 kr
Läs direkt efter köp
1 991 kr
Skickas inom 10-15 vardagar
New and Future Developments in Microbial Biotechnology and Bioengineering: Microbial Biofilms is divided into three sections: microbial adhesion/biofilms in medical settings, microbial adhesion/biofilms in agriculture, and microbial adhesion/biofilm in the environment and industry. Chapters cover adhesion and biofilm formation by pathogenic microbes on tissue and on indwelling medical devices, including sections on human infections, microbial communication during biofilm mode of growth, host defense and antimicrobial resistance, and more. Other sections cover the biofilms of agriculturally important and environmental friendly microbes, including biofilm formation on plants, in soil, and in aquatic environments.
Finally, the latest scientific research on microbial adhesion and biofilm formation in the environment and in industry is covered.
Provides an overview on the growth, structure, cell-to-cell interactions, and control/dispersal of bacterial and fungal of in vitro and in vivo biofilms Presents an overview on the microbial adhesion, biofilm formation and structures of single-species and multi-species biofilms on human tissues/medical devices, agriculture, environment and chemical industries Includes chapters on microbial biofilms of pathogenic microbes on human tissues and in medical indwelling devices Covers factors affecting microbial biofilm, adhesion and formation2 937 kr
Läs direkt efter köp
1 958 kr
Skickas inom 10-15 vardagar
2 524 kr
Läs direkt efter köp
Mushrooms are fleshy fungi with a high prospective for the production of secondary metabolites including extracellular enzymes with high agricultural and biotechnological significance. Worldwide, they are well recognized as supplementary foods due to their high nutritional values and their medicinal importance, which includes their uses in exhibiting antioxidant and antimicrobial activities, immune enhancer, and to be effective for the treatment of several diseases including diabetes and few types of cancers as well. According to recent studies, extracellular enzymes produced by several white-rot fungal strains such as Phanerochaete chrysosporium, Pleurotus sajor-caju and several mushrooms have shown a high capacity to decolorize dyes that are very harmful for the environment. Moreover, wild macrofungi have the capability to synthesize nanoparticles which are more useful for the treatment of cancer, gene therapy, DNA analysis and biosensors. Wild macrofungi areextremely important model for basic biology and commercial manufacture.
1 958 kr
Skickas inom 10-15 vardagar
2 435 kr
Läs direkt efter köp
1 633 kr
Skickas inom 10-15 vardagar
2 049 kr
Läs direkt efter köp
Pulses have played a major role in human diet and are considered a rich source of proteins. But, the major constraints in achieving the yield of pulses are the occurrences of various diseases and pests. Hence, there is a need to understand major fungal pathogens and their management strategies for sustainable agriculture. The major pulse crops in India and other Asian countries are bengal gram, pigeon pea, black gram, green gram, lentil and peas, which are attacked by several pathogens that cause considerable crop damage. Bengal gram is affected mainly by wilt (Fusarium oxysporum f. sp. ciceri), blight (Mycosphaerella pinodes) and rust (Uromyces ciceris-arietini). The main diseases of pigeon pea are wilt (Fusarium oxysporum) and Phytophtora stem blight (Phytophthora drechsleri f. sp. cajani). Powdery mildew (Erysiphe polygoni) and rust (Uromyces vicia-fabae) are the most important diseases affecting the production of pea. This volume offers details like symptoms, distribution, pathogens associated, predisposing factors and epidemiology, sources of resistance and holistic management of diseases with particular reference to those of economic importance. Several minor diseases of lentil, green gram and of black gram are discussed with their detailed and updated information. This volume provides pooled information regarding the management of major fungal phytopathogens affecting pulses.
1 633 kr
Skickas inom 10-15 vardagar
1 958 kr
Skickas inom 10-15 vardagar
2 508 kr
Läs direkt efter köp
1 958 kr
Skickas inom 10-15 vardagar
2 174 kr
Skickas inom 10-15 vardagar
2 840 kr
Läs direkt efter köp
1 849 kr
Skickas inom 10-15 vardagar
2 283 kr
Läs direkt efter köp